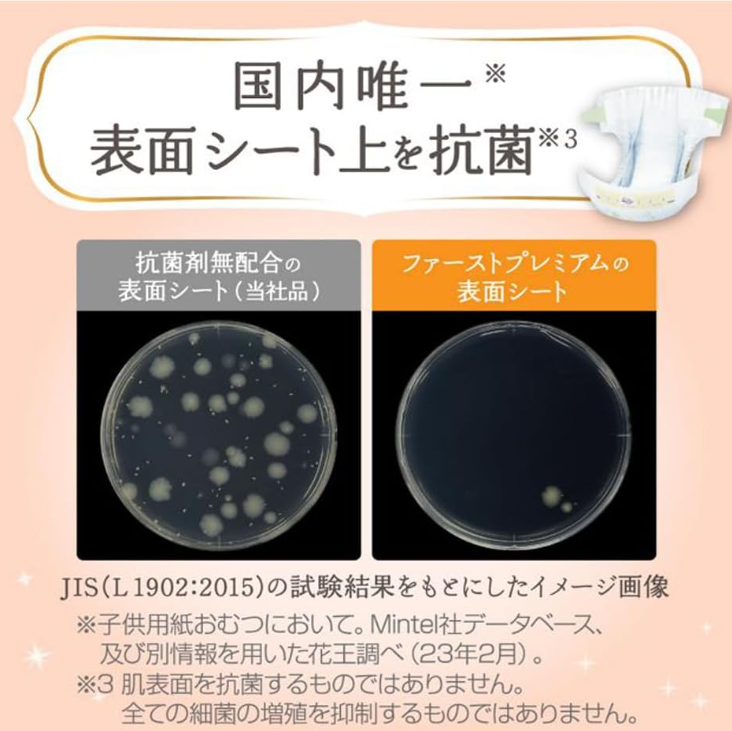

ผ้าอ้อมเด็กสำเร็จรูปแบบกางเกง KAO Merries Premium ของแท้จากญี่ปุ่น ไซส์ M 48 ชิ้น แพ็คจัมโบ้ – นุ่ม ระบายอากาศได้ดี ป้องกันการรั่วซึมแบบ 3 มิติ ผลิตในประเทศญี่ปุ่น
ยังไม่มีรีวิว

คุณลักษณะ
Japanสถานที่กำเนิด
Merriesชื่อแบรนด์
4901301388032หมายเลขรุ่น
ผ้าทอที่ไม่ใช่วัสดุ
6-11 กก.น้ำหนัก
พิมพ์ลายลักษณะ
ชนิด:ทิ้ง
การดูดซึม:ระบายอากาศที่อ่อนนุ่ม
กลุ่มอายุ:ทารก
Anti-รั่ว:3D ช่องรั่วป้องกัน
คุณสมบัติที่สำคัญ
สถานที่กำเนิด
Japan
ชื่อแบรนด์
Merries
หมายเลขรุ่น
4901301388032
วัสดุ
ผ้าทอที่ไม่ใช่
น้ำหนัก
6-11 กก.
ลักษณะ
พิมพ์ลาย
ชนิด
ทิ้ง
การดูดซึม
ระบายอากาศที่อ่อนนุ่ม
กลุ่มอายุ
ทารก
Anti-รั่ว
3D ช่องรั่วป้องกัน
บรรจุภัณฑ์และการนำส่ง
ขายหน่วย
รายการเดียว
ระยะเวลารอสินค้า
คำอธิบายผลิตภัณฑ์จากซัพพลายเออร์
คำเตือน/ข้อสงวนสิทธิ์
ผลิตภัณฑ์นี้ได้รับคุณสมบัติ/ใบอนุญาตของผลิตภัณฑ์ที่เกี่ยวข้องในบางประเทศ/ประเทศที่บังคับใช้ดูเพิ่มเติม
จำนวนสั่งซื้อขั้นต่ำ : 2,000 แพ็ค
฿200.93-265.23การคุ้มครองคำสั่งซื้อ Alibaba.com
การชำระเงินที่ปลอดภัย
ทุกการชำระเงินที่คุณทำบน Alibaba.com มีความปลอดภัยด้วยการเข้ารหัส SSL และโปรโตคอลการป้องกันข้อมูล PCI DSS ที่เข้มงวด
การคุ้มครองการคืนเงิน
รับเงินคืนหากคำสั่งซื้อไม่ถูกจัดส่ง สูญหาย หรือสินค้ามาถึงพร้อมกับปัญหาด้านคุณภาพ








